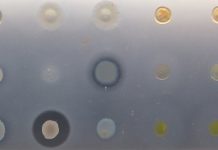

T-Mobile и Nokia готовят проект по 5G-сети
В то время как мы постепенно приближаемся к новому формату мобильной сети 5G, некоторые разработчики на рынке стараются перещеголять своих конкурентов и продемонстриро...
Uber прекращает работу над автономными электрогрузовиками
Компания-сервис каршеринга Uber сегодня оповестила общественность о том, что прекращает работу над разработкой и улучшением своего проекта по автономным электрогрузови...
Неупорядоченный графит может увеличить эффективность литий-ионных батарей
Литий-ионные аккумуляторы обладают высоким потенциальном улучшения и на данный момент остаются наиболее эффективными в применении в сравнении с другими видами аккумуля...
Найден ген, который может помочь в борьбе с раком
Современная противораковая иммунотерапия представляет собой более эффективный и многообещающий способ борьбы с раком самого разного рода, однако для многих пациентов э...
Великая пирамида Гизы может собирать электромагнитную энергию
Теоретические исследования международной группы физиков обнаружили, что Великая Пирамида Гизы может концентрировать электромагнитную энергию во внутренних камерах и под...
Стволовые клетки для борьбы с болезнью Паркинсона
Ухудшение моторных функций, вызванное такими нейродегенеративными заболеваниями, как болезнь Паркинсона, является прямым следствием определенных химических процессов в...
Sony Xperia XZ3 с поддержкой IMX586
Компания Sony известна своей нерасторопностью и даже в некотором смысле медлительностью – которая, впрочем, играет только на руку компании и ее репутации. Сегодня уже ...
Magic Leap Lumin OS — новая операционная система для VR
Одной из наиболее видимых проблем при разработке того или иного типа среды виртуальной реальности является наличие чрезмерного количества пользовательских элементов уп...
Xiaomi Pocophone F1 — первая игровая модель от Xiaomi?
Фанаты компании-производителя Xiaomi из США продолжают надеяться на то, что вскоре компания осчастливит их своим появлением на американском рынке – а потому продолжают...
Обнаружена группа бактерий с многообещающими свойствами антибиотиков
Бактерии и супербактерии продолжают оставаться наиболее заметной угрозой для человечества в контексте его выживания и медицинского обслуживания – в связи с тем, что на...